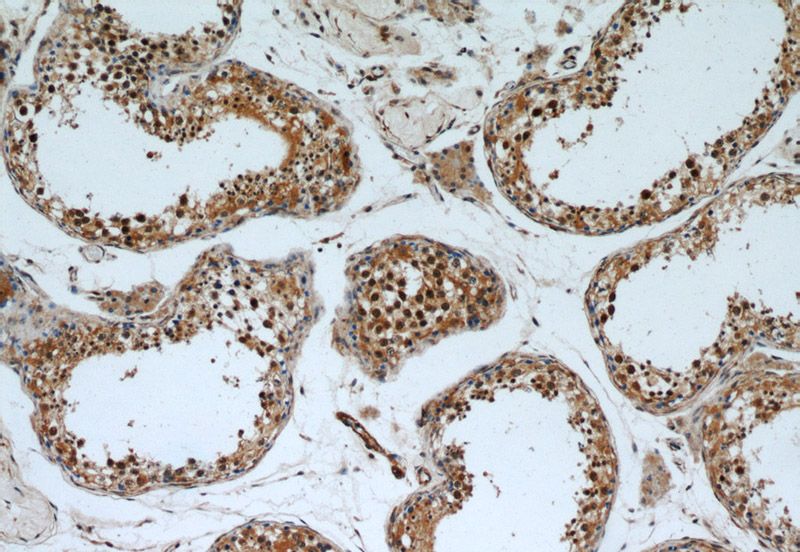
Immunohistochemical of paraffin-embedded human testis using Catalog No:109308(cIAP1 antibody) at dilution of 1:50 (under 10x lens)

-
Product Name
cIAP1 antibody
- Documents
-
Description
cIAP1 Rabbit Polyclonal antibody. Positive WB detected in mouse skeletal muscle tissue, Jurkat cells, mouse brain tissue, mouse liver tissue, mouse testis tissue. Positive IHC detected in human testis tissue, human brain tissue, human kidney tissue, human ovary tissue, human pancreas tissue, human placenta tissue, human spleen tissue. Positive IF detected in HepG2 cells. Observed molecular weight by Western-blot: 70 kDa, 55-60 kDa
-
Tested applications
ELISA, IF, WB, IHC
-
Species reactivity
Human, Mouse; other species not tested.
-
Alternative names
API1 antibody; BIRC2 antibody; C IAP1 antibody; cIAP1 antibody; Hiap 2 antibody; HIAP2 antibody; IAP 2 antibody; IAP homolog B antibody; IAP2 antibody; MIHB antibody; RING finger protein 48 antibody; RNF48 antibody
-
Isotype
Rabbit IgG
-
Preparation
This antibody was obtained by immunization of cIAP1 recombinant protein (Accession Number: NM_001166). Purification method: Antigen affinity purified.
-
Clonality
Polyclonal
-
Formulation
PBS with 0.1% sodium azide and 50% glycerol pH 7.3.
-
Storage instructions
Store at -20℃. DO NOT ALIQUOT
-
Applications
Recommended Dilution:
WB: 1:500-1:5000
IHC: 1:20-1:200
IF: 1:10-1:100
-
Validations

mouse skeletal muscle tissue were subjected to SDS PAGE followed by western blot with Catalog No:109308(cIAP1 antibody) at dilution of 1:1000
Immunohistochemical of paraffin-embedded human testis using Catalog No:109308(cIAP1 antibody) at dilution of 1:50 (under 10x lens)

Immunohistochemical of paraffin-embedded human testis using Catalog No:109308(cIAP1 antibody) at dilution of 1:50 (under 40x lens)

Immunofluorescent analysis of HepG2 cells, using BIRC2 antibody Catalog No:109308 at 1:25 dilution and Rhodamine-labeled goat anti-rabbit IgG (red).
-
Background
BIRC2 (also known as cIAP1) is a member of the inhibitor of apoptosis protein (IAP) family. The inhibitor of apoptosis (IAP) proteins are a family of anti-apoptotic regulators found in viruses and metazoans. BIRC2 is a nuclear shuttling protein, whose subcellular localization is mediated by the CRM1-dependent nuclear export pathway (PMID: 15265700). The protein is regulated transcriptionally and can be inhibited by mitochondrial proteins released in the cytoplasm upon apoptotic stimuli (PMID: 15187025). BIRC2 is also believed to be a critical regulator of vascular integrity and endothelial cell survival, thereby providing an additional target pathway for the control of angiogenesis and blood vessel homeostasis during embryogenesis, regeneration and tumorigenesis (PMID: 17934460). This BIRC2 antibody (10022-1-AP) can bind both full length (70kd) and cleaved form (60kd) of the protein.
-
References
- Santoro MM, Samuel T, Mitchell T, Reed JC, Stainier DY. Birc2 (cIap1) regulates endothelial cell integrity and blood vessel homeostasis. Nature genetics. 39(11):1397-402. 2007.
- Hinz M, Stilmann M, Arslan SÇ, Khanna KK, Dittmar G, Scheidereit C. A cytoplasmic ATM-TRAF6-cIAP1 module links nuclear DNA damage signaling to ubiquitin-mediated NF-κB activation. Molecular cell. 40(1):63-74. 2010.
- Nie D, Zhang D, Dai J. Nicotine Induced Murine Spermatozoa Apoptosis via Up-Regulation of Deubiquitinated RIP1 by Trim27 Promoter Hypomethylation. Biology of reproduction. 94(2):31. 2016.
- Wu P, Zhu X, Jin W, Hao S, Liu Q, Zhang L. Oxaliplatin triggers necrosis as well as apoptosis in gastric cancer SGC-7901 cells. Biochemical and biophysical research communications. 460(2):183-90. 2015.
- Akao Y, Nakagawa Y, Iio A, Naoe T. Role of microRNA-143 in Fas-mediated apoptosis in human T-cell leukemia Jurkat cells. Leukemia research. 33(11):1530-8. 2009.
- Varfolomeev E, Goncharov T, Fedorova AV. c-IAP1 and c-IAP2 are critical mediators of tumor necrosis factor alpha (TNFalpha)-induced NF-kappaB activation. The Journal of biological chemistry. 283(36):24295-9. 2008.
- Hostager BS, Fox DK, Whitten D. HOIL-1L interacting protein (HOIP) as an NF-kappaB regulating component of the CD40 signaling complex. PloS one. 5(6):e11380. 2010.
- Peters AL, Bishop GA. Differential TRAF3 utilization by a variant human CD40 receptor with enhanced signaling. Journal of immunology (Baltimore, Md. : 1950). 185(11):6555-62. 2010.
Related Products / Services
Please note: All products are "FOR RESEARCH USE ONLY AND ARE NOT INTENDED FOR DIAGNOSTIC OR THERAPEUTIC USE"
